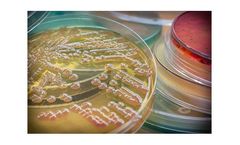
AcinetoVax - Model VXD001 - Inactivated LPS-null (endotoxin free) Whole-Cell Acinetobacter Baumannii Vaccine

- Home
- Equipment
Refine by
Acinetovax Environmental Equipment & Supplies
1 equipment items found
Manufactured by:Vaxdyn, S. L. based inDos Hermanas (Sevilla), SPAIN
Active principle: Inactivated LPS-null (endotoxin free) whole-cell Acinetobacter baumannii vaccine. Stage: Preclinical development. Indication: Raise active immunity against 100% of circulating strains of Acinetobacter baumannii, in the population in hospitals or the community at risk of developing infections by A. baumannii. Highlights: Multi-antigen presentation leads to potent humoral and ...